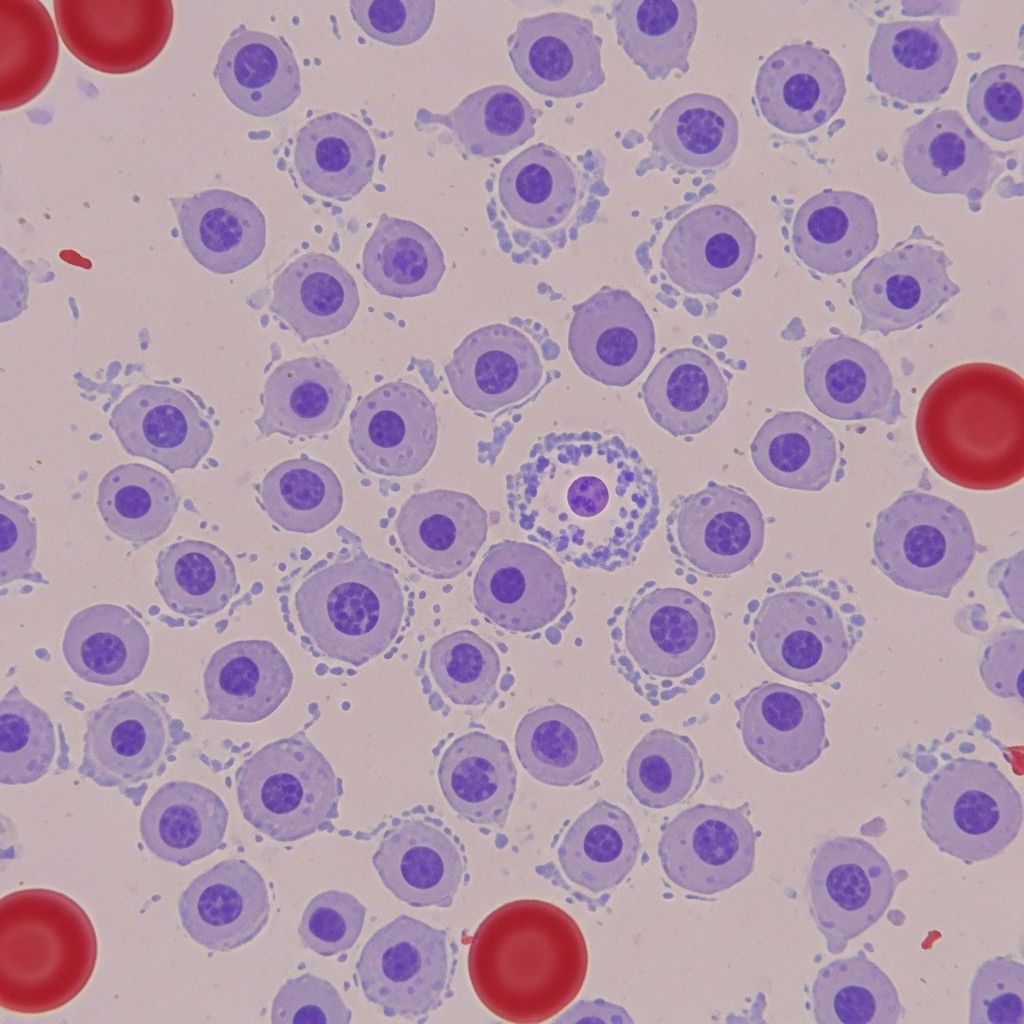

Understanding B-Cell Prolymphocytic Leukemia (B-PLL): Diagnosis, Symptoms, Treatment, and Outlook
Comprehensive guide on B-Cell Prolymphocytic Leukemia: causes, symptoms, diagnosis, treatment options, and living with B-PLL.
B-Cell Prolymphocytic Leukemia (B-PLL): What You Need to Know
B-cell prolymphocytic leukemia (B-PLL) is an aggressive, rare type of blood cancer originating from B-lymphocytes. B-PLL accounts for less than 1% of all cases of lymphocytic leukemias. This comprehensive guide covers what B-PLL is, its causes, symptoms, diagnosis, risk factors, treatment strategies, and living with the disease.
What is B-Cell Prolymphocytic Leukemia (B-PLL)?
B-PLL is a malignancy where the bone marrow produces an excessive number of abnormal mature white blood cells (prolymphocytes), which accumulate in the blood and bone marrow. These abnormal cells proliferate rapidly, leading to overcrowding and disruption of normal blood cell function. B-PLL is distinct from other leukemias due to its unique cellular characteristics and clinical progression, which tends to be more aggressive.
- Prevalence: Extremely rare, accounting for only a small fraction of lymphoid leukemias.
- Main affected population: Predominantly older adults; median age at diagnosis is around 69 years.
- Gender: Occurs more frequently in individuals assigned male at birth.
Symptoms and Signs of B-PLL
B-PLL symptoms are often nonspecific and can overlap with other lymphoid blood cancers. Some people may have mild or no symptoms early in the disease, which can lead to delayed diagnosis.
Common Symptoms
- Fatigue: Persistent tiredness not relieved by rest.
- Fever and Night Sweats: Unexplained high body temperature and sweating at night.
- Unintentional Weight Loss: Losing weight without diet or exercise changes.
- Frequent Infections: Due to low numbers of healthy white blood cells.
- Shortness of Breath: Resulting from anemia as healthy cells are crowded out.
Physical Signs Detected by Doctors
- Splenomegaly: Enlarged spleen, often causing discomfort or fullness in the left upper abdomen.
- Anemia: Low red blood cell count, contributing to fatigue and pallor.
- Thrombocytopenia: Low platelet count, which can lead to easy bruising or bleeding.
- Lymphocytosis: High levels of lymphocytes (abnormal B-cells) in the blood.
- Enlarged Lymph Nodes: Swelling in the neck, armpits, or groin (less common than in some other leukemias).
Causes of B-PLL
The exact cause of B-PLL remains unclear, but genetic mutations are thought to play a central role. These mutations occur in the DNA of precursor B-cells within the bone marrow, resulting in the production of abnormal, rapidly dividing prolymphocytes.
- Genetic mutations: Errors in genes controlling cell growth and survival are suspected.
- Disease progression: In some cases, B-PLL appears to arise from the transformation of a previously slow-growing blood cancer, such as chronic lymphocytic leukemia (CLL).
Risk Factors
Certain risk factors may increase the likelihood of developing B-PLL, though the disease can occur without any known risk factors.
- Age: Most people diagnosed are older, with a median age of 69 years.
- Gender: More common in people assigned male at birth.
- Family history: A family history of blood or bone marrow cancers may raise the risk.
- Other factors: Overall, no specific lifestyle or environmental risks have been identified.
Diagnosing B-PLL
No single test can diagnose B-PLL due to its overlap with other blood cancers like CLL and mantle cell lymphoma. A diagnosis requires a combination of thorough clinical evaluation and laboratory testing.
- Medical History and Physical Exam: Review of symptoms, past illnesses, family history, and a comprehensive physical assessment.
- Laboratory Tests:
- Blood Tests: To check for abnormal lymphocyte levels, anemia, and low platelets.
- Bone Marrow Biopsy: Examination of marrow samples to identify abnormal cell populations.
- Peripheral Blood Smear: Evaluation of blood under a microscope to identify prolymphocytes.
- Immunophenotyping: Laboratory process that analyzes proteins on the surface of cells to distinguish B-PLL from similar conditions.
- Cytogenetic and Molecular Testing: Identify chromosomal changes or mutations (e.g., TP53 mutation), which may impact treatment decisions.
B-PLL is typically diagnosed when at least 55% of lymphocytes in the blood sample are prolymphocytes.
Treatment Options for B-PLL
Because B-PLL is rare, there is no universally established treatment protocol. Treatment approaches are tailored to individual patient factors and may involve participation in clinical trials. The primary goal is to reduce abnormal cell levels, manage symptoms, and try to achieve remission.
Main Treatment Strategies
- Watchful Waiting/Active Surveillance: For patients without symptoms or high-risk features, doctors may recommend close monitoring with regular blood tests until signs of disease progression.
- Chemotherapy: Combination regimens such as FCR (fludarabine, cyclophosphamide, rituximab) or BR (bendamustine, rituximab) are commonly used. However, B-PLL often develops resistance to standard chemotherapies.
- Targeted Therapy:
- Alemtuzumab (Campath): May be effective, especially for patients with the TP53 mutation.
- Ibrutinib (Imbruvica) and Idelalisib (Zydelig): Newer targeted therapies showing promise, though not all are approved specifically for B-PLL.
- Hematopoietic Stem Cell Transplantation: Reserved for select patients (usually younger and in good health) who respond to prior treatments. This approach has curative potential but involves significant risks and is not suitable for most patients.
- Participation in Clinical Trials: Given the rarity of B-PLL, patients are often encouraged to join research studies testing new therapeutic agents or combinations.
Supportive Care
- Blood transfusions: For anemia or low platelets.
- Infection prevention and management: Due to weakened immunity.
- Symptom control: Medications to manage pain, reduce fever, and control other symptoms.
Prognosis and Life Expectancy
B-PLL is a challenging cancer to treat, primarily due to its aggressive progression and possible resistance to conventional therapies. Prognosis depends on multiple factors, including patient age, genetic mutations (such as presence of TP53), overall health, and response to treatment. While the disease is associated with a poorer prognosis than many other leukemias, newer therapies and supportive care have improved survival for some patients.
Living With B-PLL
A diagnosis of B-PLL can significantly impact quality of life. Many patients face emotional and psychological stress, in addition to physical symptoms. Support from healthcare professionals, access to peer support groups, and clear communication about treatment aims and side effects are important for optimal care.
Tips for Coping
- Maintain open communication with your healthcare team.
- Seek emotional and psychological support if needed.
- Participate actively in treatment decisions.
- Stay informed about your disease and treatment options.
- Consider joining support groups for people with rare leukemias.
Frequently Asked Questions (FAQs)
What are the first symptoms of B-PLL?
The earliest signs are often vague, such as fatigue, night sweats, or unintentional weight loss. Enlarged spleen or lymph nodes may be present, but some cases are detected through routine blood tests before symptoms appear.
How is B-PLL different from chronic lymphocytic leukemia (CLL)?
While both are types of B-cell leukemias, B-PLL is more aggressive, with more rapid progression and a higher percentage of prolymphocytes in the blood. B-PLL typically shows resistance to standard therapies used for CLL.
Is B-PLL curable?
B-PLL is rarely considered curable. Stem cell transplantation may provide a cure for selected patients, but for most, the focus is on controlling the disease, improving quality of life, and managing symptoms.
What does “watchful waiting” mean in B-PLL?
This approach involves close monitoring without immediate active treatment, suitable for patients who don’t have significant symptoms or organ impairment. Treatment starts only when the disease progresses or symptoms develop.
Are there emerging therapies for B-PLL?
Yes, several new therapies—especially targeted drugs like kinase inhibitors—are under investigation. Participation in clinical trials is strongly encouraged to access cutting-edge treatments.
Summary Table: Key Features of B-PLL
Feature | B-PLL |
---|---|
Median age at diagnosis | 69 years |
Gender predominance | More common in males |
Key symptoms | Fatigue, fever, weight loss, night sweats, infections |
Main diagnostic criteria | ≥55% prolymphocytes in blood |
Treatment options | Chemotherapy, targeted therapy, watchful waiting, stem cell transplant |
Prognosis | Generally poor, but improving with newer therapies |
When to Seek Medical Attention
If you experience persistent, unexplained symptoms such as fever, night sweats, fatigue, weight loss, or easy bruising, seek prompt medical evaluation. Early detection, accurate diagnosis, and personalized management are essential for best outcomes in B-PLL.
Resources and Support
- Consult with a hematologist-oncologist experienced in rare leukemias.
- Reach out to patient advocacy organizations specializing in blood cancers.
- Consider speaking with a genetic counselor if you have a family history of hematological cancers.
- Review current clinical trial options with your healthcare team.
References
- https://www.healthline.com/health/leukemia/b-pll-leukemia
- https://en.wikipedia.org/wiki/B-cell_prolymphocytic_leukemia
- https://healthtree.org/b-cell-prolymphocytic-leukemia/community/what-are-the-signs-and-symptoms-of-b-cell-prolymphocytic-leukemia
- https://www.medicalnewstoday.com/articles/b-cell-prolymphocytic-leukemia
- https://bloodcancerunited.org/blood-cancer/leukemia/b-cell-prolymphocytic-leukemia-b-pll
- https://pubmed.ncbi.nlm.nih.gov/37187496/
- https://ashpublications.org/blood/article/140/Supplement%201/6668/492480/Treatment-and-Overall-Survival-Outcomes-of
- https://healthtree.org/b-cell-prolymphocytic-leukemia/community/what-is-b-cell-prolymphocytic-leukemia
- https://rarediseases.info.nih.gov/diseases/8223/b-cell-prolymphocytic-leukemia
Read full bio of Sneha Tete